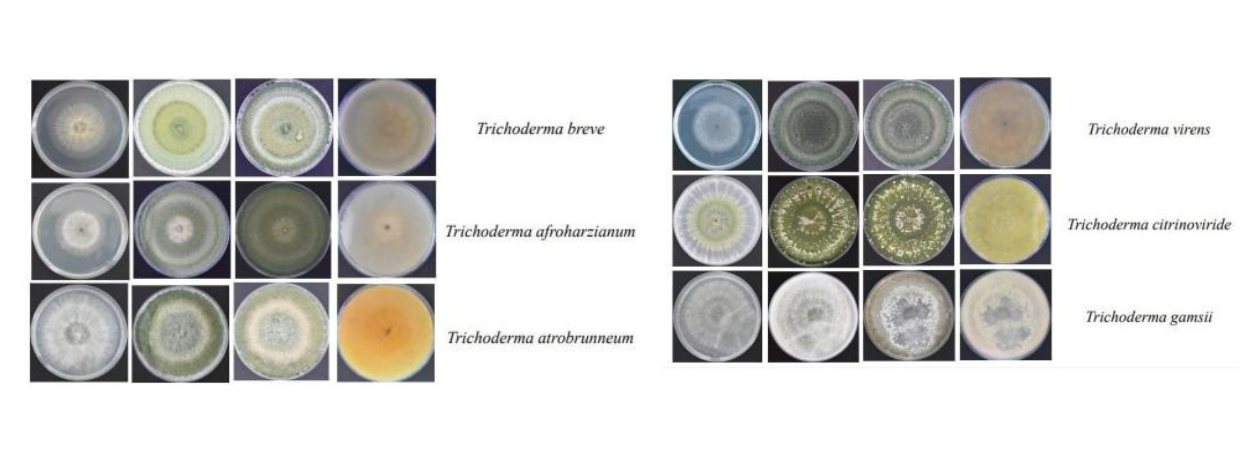

A new study, jointly conducted by a group of researchers from the University of Malta and the National Research Council in Italy, recorded six species of Trichoderma on the Maltese islands.
Trichoderma is a group of fungi that freely inhabit soil, and survive by decomposing word and other cellulose-rich plant debris. As they need light to form spores, they may be encountered as powdery green growth on the surfaces of decaying wood.
One of them, the Trichoderma breve – was documented in Europe for the first time ever.
The other five species are:
The Trichoderma citrinoviride The Trichoderma virens The Trichoderma gamsii The Trichoderma afroharzianum The Trichoderma atrobrunneum
Trichoderma fulfil the ecological function of breaking down organic matter and recycling nutrients. They also help plants overcome environmental stresses such as drought, intense UV radiation and salinity.
The researchers said that there are commercial applications in agriculture for these fungi – the combating of certain plant pathogens and bioremediation.
For the study, soil samples collected from various substrates and locations, were screened for the presence of Trichoderma. Over 21 days, colony growth patterns and isolate colours were documented.
Trichoderma were identified through a technique called DNA barcoding where parts of its genetic material were read and compared to a library of genetic codes of different Trichoderma species.
The researchers were Prof. Joseph Buhagiar from the Department of Biology at UM, Mr Marco Iannaccone, and Stefania Somma and Claudio Altomare from the National Research Council in Italy.